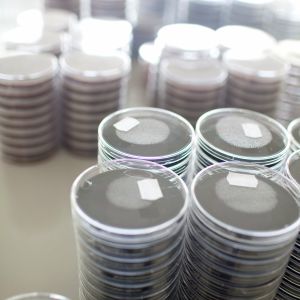
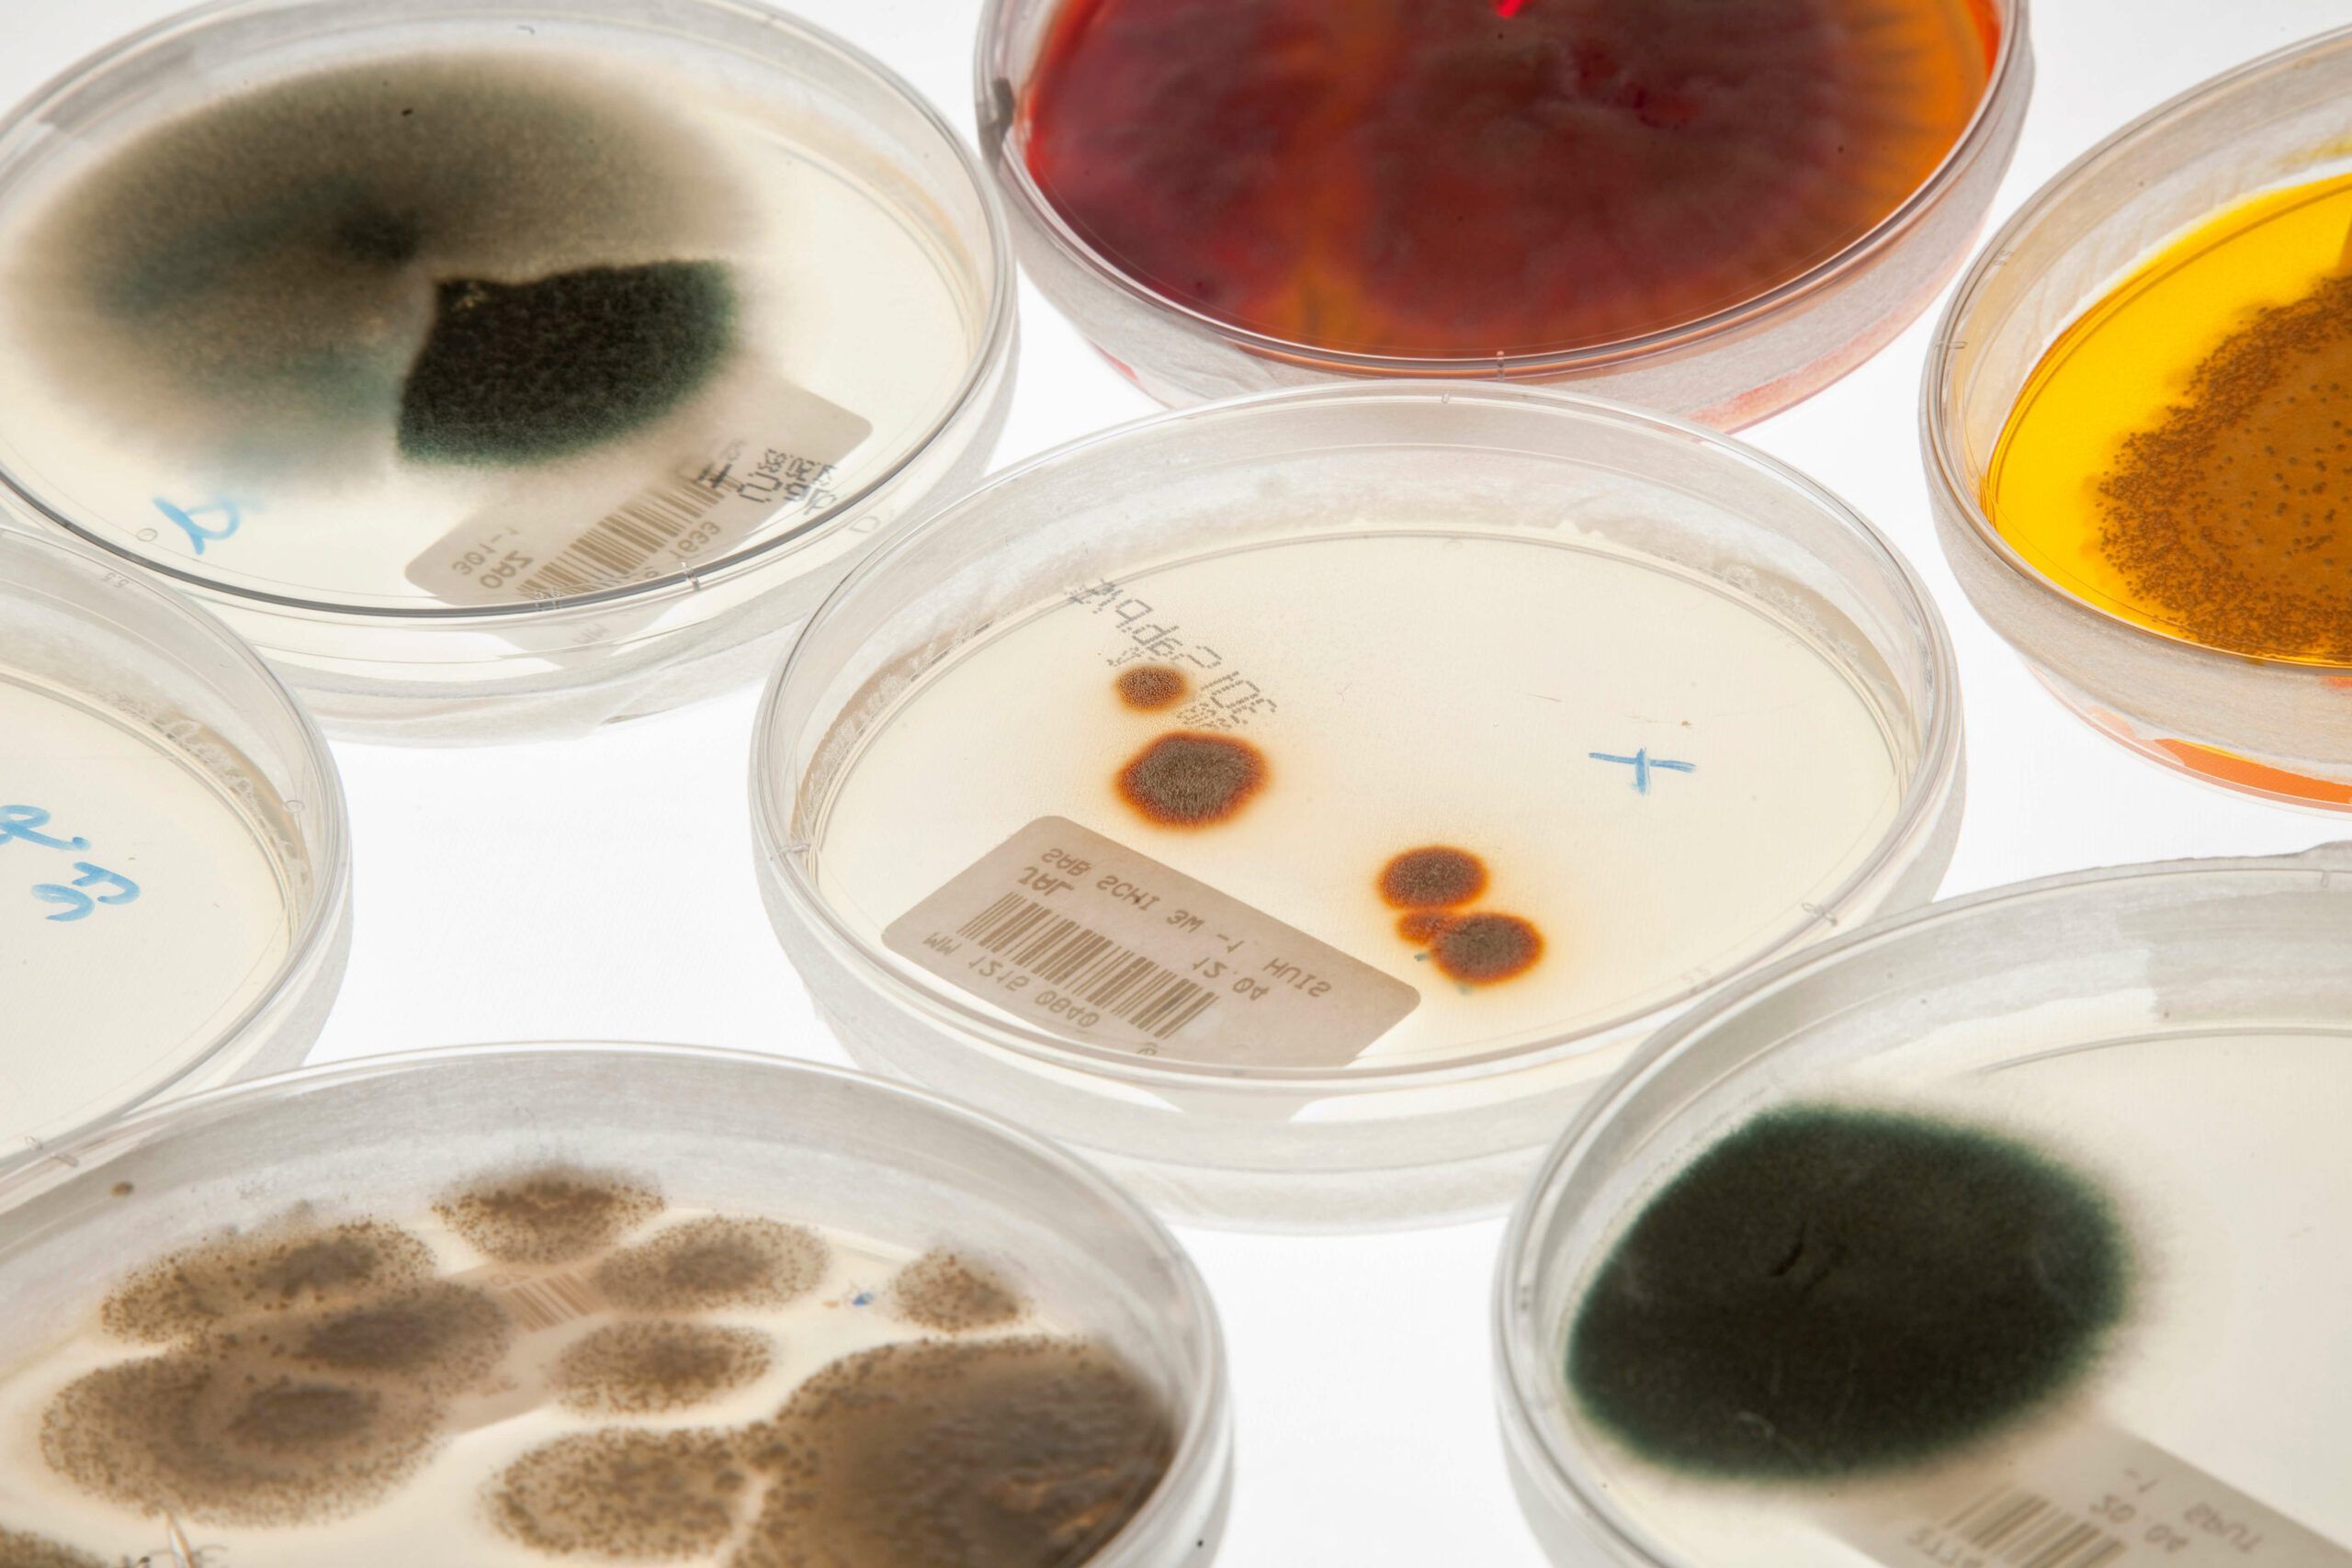

Resistente bacteriën
Antibiotica zijn medicijnen die werken tegen infecties door bacteriën. Ze doden ze of remmen hun groei. Helaas kunnen bacteriën zich snel en efficiënt aanpassen aan veranderende omstandigheden. Tijdens een behandeling met antibiotica kunnen bacteriën, die zich aangepast hebben aan de aanwezigheid van het antibioticum, overleven in het lichaam van de patiënt. Deze bacteriën zijn dan ongevoelig geworden voor de behandeling met het antibioticum. We spreken dan ook van (antibioticum) resistente bacteriën. Wanneer een bacterie resistent is, zijn er nog maar weinig antibiotica voorhanden waarmee de infectie behandeld kan worden.
Gebruik antibiotica
Steeds meer bacteriën reageren niet meer goed op antibiotica. Dat komt omdat er in de wereld veel antibiotica worden gebruikt. Oorzaken hiervan zijn onder andere de toename van de wereldbevolking en het gebruik van antibiotica in de voedingsindustrie. Maar ook de toename van het aantal mensen dat meer vatbaar is voor infecties, denk daarbij aan de vergrijzing van de bevolking en de toenemende complexe medische behandelingen, liggen daaraan ten grondslag. In ziekenhuizen verblijven veel patiënten die antibiotica nodig hebben. Het is dus niet verwonderlijk dat juist op die plekken ook veel resistente bacteriën voorkomen.
Omdat de toename van resistente bacteriën in de hand wordt gewerkt door het veelvuldig gebruik van antibiotica, is het van het grootste belang om alleen medicatie voor te schrijven aan patiënten die dat ook echt nodig hebben. Verstandig gebruik van antibiotica kan de ontwikkeling van resistente bacteriën namelijk een halt toeroepen. Daarnaast moet worden voorkomen dat resistente bacteriën zich kunnen verspreiden binnen bijvoorbeeld een ziekenhuis.
Voorbeelden
Een voorbeeld van een resistente bacterie is de VRE (=vancomycine resistente enterokok). Op deze pagina vindt u via deze link antwoorden op veelgestelde vragen over deze bacterie.
Resistentie ontwikkeling E.coli tegen de belangrijkste antibiotica
In deze figuur is de resistentie ontwikkeling te zien van E.coli tegen de belangrijkste antibiotica.
